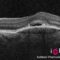

Tratamientos
CATARATAS

Cirugía de cataratas

Lentes intraoculares
CONJUNTIVA

Cirugía Pterigion
CÓRNEA

Queratocono

Crosslinking

Trasplante de córnea

Trasplante Membrana Amniótica
ESTÉTICA

Blefaroplastia

Neuromodulación

Ácido Hialurónico
ESTRABISMO

Cirugía estrabismo
GLAUCOMA

Cirugía glaucoma

Iridotomía Láser

Trabeculoplastia láser

Implante de drenaje
LÁSER

Tratamientos con láser

Iridotomía láser

Trabeculoplastia láser

Capsulotomía Yag láser

Láser de retina
PÁRPADOS

Orzuelos y chalación

Xantelasma

Blefaroplastia

Blefaritis
PRESBICIA

Vista cansada
REFRACTIVA

Cirugía refractiva

Vista cansada

Implante lente Visian ICL

Láser excimer: Lasik

Láser excimer

Cirugía del cristalino
RETINA

Retina y vítreo

Láser de retina

Desprendimiento de retina
Inyecciones intravítreas

Vitrectomía
LUZ PULSADA

Ojo seco

Blefaritis
Contacta con nosotros
El INSTITUTO OFTALMOLÓGICO HOYOS abre las puertas para atender a las necesidades de su salud ocular.